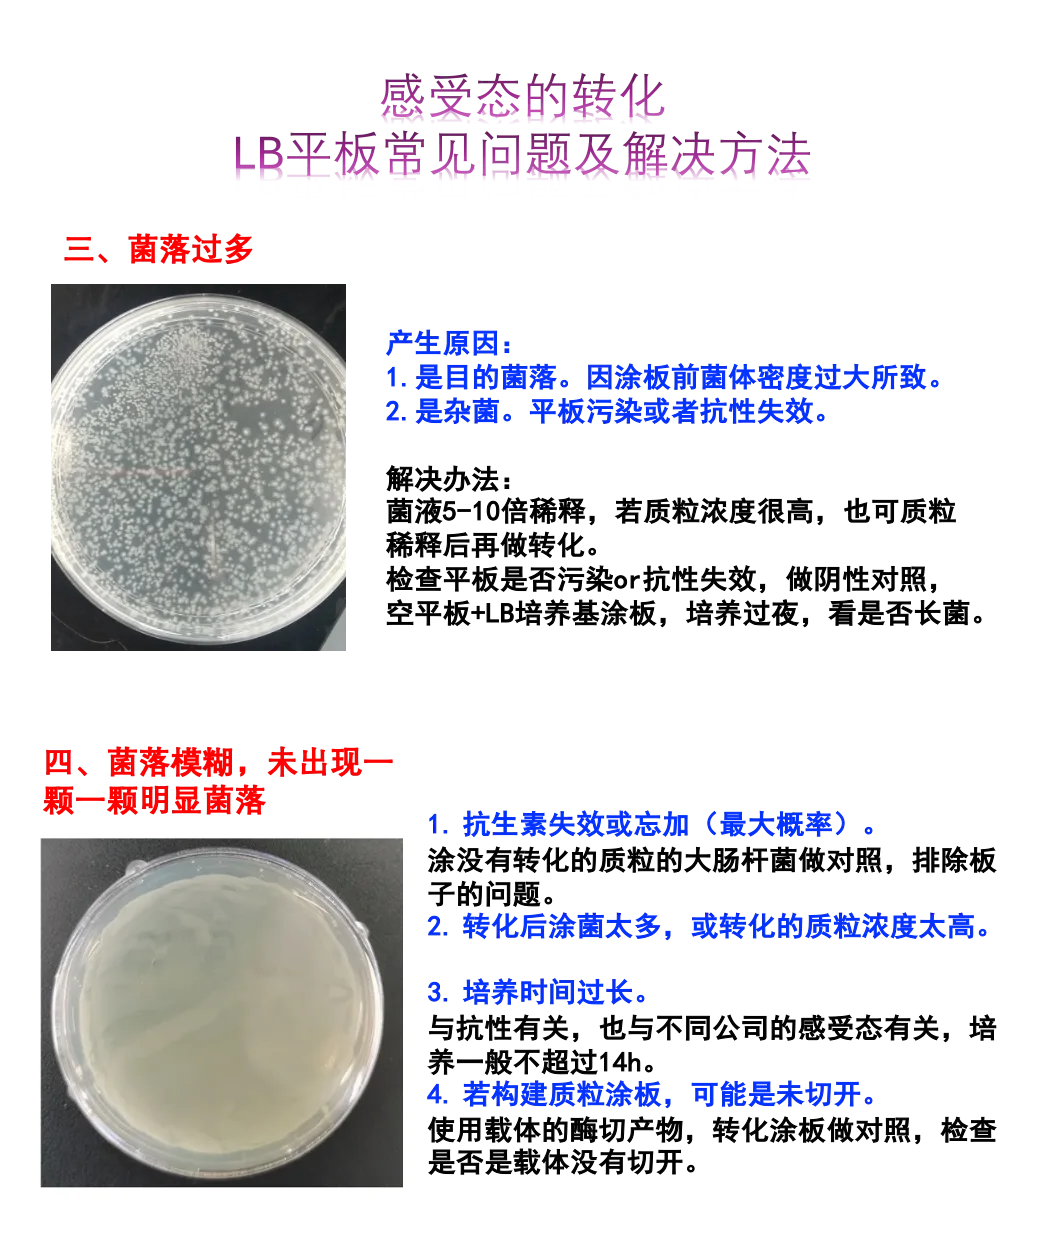

✅今日分享:感受态转化时,LB平板常见问题和解决方法(图1图2的总结~)
⚠️除此之外,还有涉及操作和一些常见的注意事项如下:(图片版本-图3)👇🏼
1. 进行无菌操作,避免外源菌和DNA的污染。
2. 所有操作均低温进行,感受态要在冰上放置,全程冰上操作。
3. 灭菌好LB培养基后,加入抗生素时要注意温度,在手可以触碰灭菌瓶时的温度时即可加入抗生素,避免过高温度导致抗生素失活。
4. 所使用的试剂和器皿都应具备高纯度,并进行灭菌处理,灭好菌4度保存。
5. 严格控制感受态的用量,质粒的用量,以提高转化效率,质粒100ng左右即可,感受态使用量建议看对应说明书,扩增质粒使用10-20ul,构建质粒使用50-100ul。
6. 做转化最好做阴性对照,即LB,空感受态分别涂板,以及空平板培养。
7. 加抗生素的LB平板4度保存一个月没问题;37度16h小时左右即失活,培养最好不要超过14h。
8.抗生素使用浓度:可100ug/ml,配制母液浓度为100mg/mL的储备溶液,使用时1比1000加即可。
(称量100mg抗生素粉末溶于1毫升水中,涡旋溶解,并过滤灭菌。)
9.对于细菌的长期储存,可选择甘油。
(菌液:甘油=4:1,长期储存于负80冰箱。)

吃瓜被毒死
用100ug的质粒做转化吗,,这是不是有点太多了呀